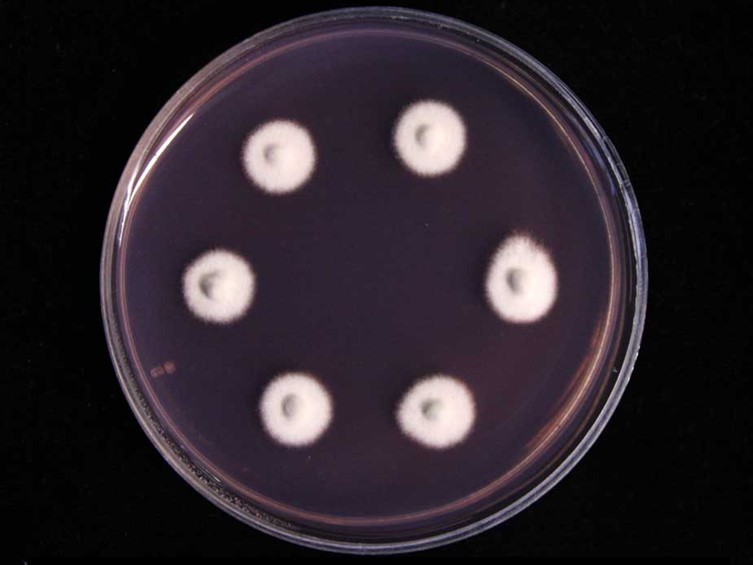

Description:
Specimens were found on hunting spiders (e.g. crab spiders, Thomisidae) attached to the underside of living leaves of forest plants.  Synnemata white to grayish white mycelia completely covering the thorax and abdomen of the host, sometimes extending to the legs. Synnemata numerous, erect, simple, up to 6 mm high and 50 μm in diam, brown at the sterile base, becoming gray-white with
Synnemata white to grayish white mycelia completely covering the thorax and abdomen of the host, sometimes extending to the legs. Synnemata numerous, erect, simple, up to 6 mm high and 50 μm in diam, brown at the sterile base, becoming gray-white with  conidia.
conidia.  Phialides one to several on each metula, crowded, smooth-walled, obovoid when immature to ellipsoid, 4-5.5 × 3-3.5 μm, with a long neck, 2.5-3 × 0.5-1 μm. Conidia catenate, one-celled, smooth-walled, hyaline, clavate, 4.5-5.5 × 1-1.5 μm.
Phialides one to several on each metula, crowded, smooth-walled, obovoid when immature to ellipsoid, 4-5.5 × 3-3.5 μm, with a long neck, 2.5-3 × 0.5-1 μm. Conidia catenate, one-celled, smooth-walled, hyaline, clavate, 4.5-5.5 × 1-1.5 μm.
Culture characteristics:
Colonies on PDA are slow-growing, attaining a diam of 10–15 mm in 21 d at 22 °C with white aerial mycelia. There was no sign of sporulation in culture but it produces a pallid wine-red pigment diffusing into the agar.
Colonies on PDA are slow-growing, attaining a diam of 10–15 mm in 21 d at 22 °C with white aerial mycelia. There was no sign of sporulation in culture but it produces a pallid wine-red pigment diffusing into the agar.
Reference:
Hywel-Jones NL (1996). Akanthomyceson spiders in Thailand. Mycological Research 100: 1065–1070.
DOI: https://doi.org/10.1016/S0953-7562(96)80214-0Luangsa-ard JJ, Tasanathai K, Mongkolsamrit S et al. (2010). Akanthomyces koratensis Hywel-Jones. In: Atlas of invertebrate-pathogenic fungi of Thailand Volume 3. National Center for Genetic Engineering and Biotechnology, National Science and Technology Development Agency: 24–25.
Species |
Strain |
Compound |
Pubchem CID |
Biological activity |
Reference |
|---|
|
Strain |
ITS | LSU | RPB1 | RPB2 | TEF1 |
|---|---|---|---|---|---|
| NHJ 2662 | GQ250008 | GQ249982 | ON470206 | ON470208 | GQ250032 |
| NHJ 666.01 | GQ250010 | GQ249981 | - | - | GQ250031 |